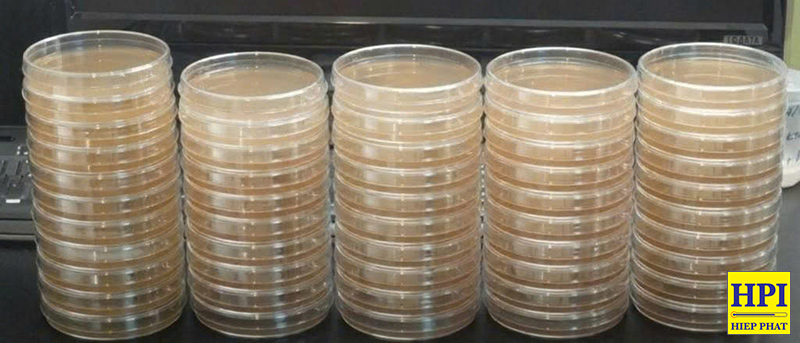
Cách Tiệt Trùng Đĩa Petri Nuôi Cấy Agar Đã Qua Sử Dụng Bằng Nồi Hấp Tiệt Trùng

Cách Tiệt Trùng Đĩa Petri Nuôi Cấy Agar Đã Qua Sử Dụng Bằng Nồi Hấp Tiệt Trùng
Đĩa Petri đóng vai trò thiết yếu trong các phòng thí nghiệm vi sinh, được sử dụng để nuôi cấy các loại vi khuẩn, nấm và các dạng vi sinh vật khác nhau. Mặc dù quy trình nuôi cấy tương đối đơn giản, nhưng việc xử lý và làm sạch sau khi sử dụng lại tiềm ẩn nhiều nguy cơ. Việc tiệt trùng đĩa Petri nuôi cấy agar đã qua sử dụng một cách an toàn là bắt buộc nhằm ngăn chặn sự lây lan của vi sinh vật nguy hại ra môi trường xung quanh phòng thí nghiệm.
Tại sao bắt buộc phải tiệt trùng đĩa petri nuôi cấy agar đã qua sử dụng?
Tiệt trùng thạch agar trên đĩa petri sau khi sử dụng là bắt buộc để để tiêu diệt hết vi sinh vật (vi khuẩn, nấm) đã cấy và cả những vi khuẩn nhiễm bẩn khác trên đĩa, ngăn ngừa vi sinh vật sinh sôi, phát triển, lây lan ra môi trường, có khả năng gây ra lây nhiễm chéo trong phòng lab. Dưới đây là một số lý do chính cần tiệt trùng đĩa petri nuôi cấy agar sau khi sử dụng:
Kiểm soát nguy cơ lây nhiễm chéo giữa các mẫu
Vi sinh vật có khả năng sinh trưởng mạnh mẽ trên môi trường thạch chứa nhiều chất dinh dưỡng. Nếu không được tiệt trùng đúng cách, các tác nhân này có thể di chuyển sang các đĩa nuôi cấy khác hoặc bám vào thiết bị thí nghiệm, gây ảnh hưởng nghiêm trọng đến độ chính xác của kết quả nghiên cứu.
Đảm bảo tiêu chuẩn an toàn sinh học trong phòng lab
Tiệt trùng đĩa thạch agar đúng cách giúp loại bỏ các vi sinh vật có khả năng gây bệnh tiềm tàng trong đĩa nuôi cấy, qua đó bảo vệ sức khỏe của nhân viên phòng thí nghiệm và giữ gìn sự an toàn cho môi trường xung quanh khu vực làm việc.
Tiêu diệt triệt để mọi dạng vi sinh vật
Phương pháp sử dụng nhiệt độ cao kết hợp với áp suất trong nồi hấp tiệt trùng là giải pháp duy nhất có khả năng tiêu diệt hoàn toàn mọi loại vi sinh vật, kể cả những chủng có sức đề kháng cao như bào tử của vi khuẩn.
Xử lý chất thải và tái chế dụng cụ thí nghiệm
Khử trùng đảm bảo xử lý an toàn đĩa Petri cùng các vật dụng liên quan trước khi tiến hành thanh lý hoặc tái sử dụng, đồng thời đáp ứng đầy đủ các tiêu chuẩn vô trùng bắt buộc trong môi trường phòng thí nghiệm chuyên nghiệp.
Nguyên lý tiệt trùng đĩa Petri nuôi cấy agar đã qua sử dụng
Để tiệt trùng đĩa petri nuôi cấy agar đã qua sử dụng, bạn có thể sử dụng phương pháp hấp tiệt trùng với nồi hấp. Trước hết, bạn cần rửa sạch, tráng kỹ và sau đó hấp tiệt trùng trong nồi hấp tiệt trùng ở nhiệt độ 121° trong 15-20 phút. Khi nhiệt độ nồi hấp tăng lên 121-135°C dưới áp suất 15-30 psi (1-2 bar), hơi nước thâm nhập vào vật liệu và làm biến tính protein của vi sinh vật, phá hủy cấu trúc tế bào và DNA của chúng.
Quá trình này hiệu quả hơn nhiều so với tiệt trùng khô vì hơi nước truyền nhiệt nhanh hơn không khí và có khả năng tiêu diệt cả bào tử vi khuẩn cứng đầu nhất.
Áp dụng cho các loại đĩa petri thủy tinh, hoặc các loại đĩa petri nhựa có độ nóng chảy cao, có thể tái sử dụng nhiều lần sau khi hấp tiệt trùng.
*Lưu ý: Một số loại đĩa Petri nhựa dùng một lần, được sản xuất từ Polystyrene – loại vật liệu sẽ tan chảy khi nhiệt độ vượt quá 50°C sẽ không thể tái sử dụng sau khi hấp tiệt trùng hơi nước.
Tham khảo bài viết Tại Sao 121 Độ C Là Nhiệt Độ Hấp Tiệt Trùng Tiêu Chuẩn?
Các Bước Thực Hiện Tiệt Trùng Đĩa Petri, đĩa thạch Agar
Bước 1: Thu thập đĩa sau sử dụng
Tập hợp tất cả các đĩa Petri đã qua nuôi cấy còn chứa môi trường. Cần giữ nguyên trạng thái đậy kín của đĩa để hạn chế tối đa nguy cơ phát tán vi sinh vật ra bên ngoài.
Bước 2: Sắp xếp đĩa petri chứa agar vào giỏ tiệt trùng
Tháo nắp đĩa và đặt riêng sang một bên. Đặt phần chứa agar vào giỏ chứa mẫu tiệt trùng chuyên dụng, sau đó xếp các nắp đĩa lên trên cùng.

Bước 3: Chuẩn bị giỏ tiệt trùng dạng xô hoặc giỏ có đế đỡ
Sử dụng xô hoặc đặt đế đỡ vào trong giỏ đựng mẫu chuyên dụng, sau đó rót nước vào khoảng một nửa chiều cao của đế. Chức năng của đế đỡ là nâng giỏ đục lỗ lên khỏi mặt nước, cho phép agar tan chảy rơi xuống dưới trong quá trình hấp. Lượng nước này cũng giúp thu gom agar đã tan và ngăn không cho chất liệu đông cứng trong xô.
Bước 4: Đặt giỏ chứa đĩa petri đã qua sử dụng vào trong nồi hấp
Đưa xô hoặc giỏ có đáy đã chứa nước vào trong buồng tiệt trùng. Tiếp đến, đặt giỏ lưới có chứa đĩa Petri đã tháo rời lên trên đế đỡ.

Bước 5: Vận hành chu kỳ tiệt trùng đĩa petri, đĩa chứa agar
Đóng kín nồi hấp tiệt trùng và khởi động chu trình tiệt trùng tiêu chuẩn ở 121 độ C, trong khoảng thời gian tối thiểu 20 phút. Lưu ý rằng thời lượng có thể thay đổi tùy theo khối lượng đĩa Petri và agar cần xử lý.
Bước 6: Lấy giỏ ra sau khi hoàn tất
Sau khi chu trình kết thúc và nhiệt độ trong nồi đã hạ xuống mức an toàn, tiến hành lấy giỏ ra. Cần thận trọng với hơi nước nóng, chất lỏng và nhiệt độ môi trường xung quanh.
*Đối với các dòng nồi hấp của hãng ALP đã được tích hợp sẵn tính năng chỉ có thể mở nắp sau khi nhiệt độ dưới 80°C nhằm giúp người sử dụng hạn chế bị bỏng bởi nhiệt độ hơi nước sau tiệt trùng.
Bước 7: Quan sát kết quả
Với các loại đĩa petri thủy tinh và đĩa nhựa sử dụng nhiều lần, sau quá trình tiệt trùng, phần lớn agar đã được hòa tan vào nước trong xô, có thể lấy ra, bảo quản và tái sử dụng bình thường.
Đối với các đĩa Petri nhựa sử dụng một lần, sau khi tiệt trùng sẽ có hiện tượng bị nóng chảy và biến thành một khối đặc. Một phần agar có thể dính vào nhựa, tuy nhiên phần lớn agar đã hòa tan vào nước trong xô. Mặc dù đã được khử trùng hoàn toàn, vẫn nên tránh tiếp xúc trực tiếp với các vùng từng chứa agar để đảm bảo vệ sinh.
Bước 8: Xử lý chất thải
Đổ nước lẫn agar, vứt bỏ khối nhựa đã đông cứng (đối với đĩa petri nhựa dùng một lần) vào bồn chứa chất lỏng sinh học nguy hại hoặc hệ thống cống rãnh có khả năng xử lý an toàn. Phương pháp này đảm bảo sạch sẽ và không gây bừa bộn.
Một số câu hỏi thường gặp khi tiệt trùng đĩa petri, đĩa thạch agar
Dưới đây là một vài câu hỏi thường gặp về quá trình tiệt trùng đĩa petri đã qua sử dụng:
Tại sao bắt buộc phải sử dụng nồi hấp trong tiệt trùng đĩa petri đã qua sử dụng?
Có nhiều phương pháp thay thế được đề cập như sử dụng lò vi sóng hoặc hóa chất tẩy mạnh. Tuy nhiên, những phương pháp này chỉ có thể tiêu diệt một phần vi khuẩn do khả năng kháng nhiệt và hóa chất của một số chủng vi sinh vật. Để đạt được điều kiện tiệt trùng thực sự cho đĩa Petri và agar, nồi hấp là thiết bị không thể thay thế, bởi chỉ có sự kết hợp giữa nhiệt độ cao, độ ẩm và áp suất mới có thể loại bỏ hoàn toàn mọi loại vi sinh vật, kể cả những chủng có khả năng tồn tại trong điều kiện khắc nghiệt.
Có nên sử dụng túi chứa chất tải sinh học khi tiệt trùng đĩa petri, đĩa agar không?
Một phương án khác thường được áp dụng là cho đĩa Petri vào túi chứa rác thải sinh học rồi tiến hành hấp tiệt trùng. Mặc dù phương pháp này có hiệu quả khử trùng, nhưng tồn tại nhược điểm lớn là agar lỏng trộn lẫn với vật liệu sinh học dễ bị rò rỉ, gây bẩn trong phòng thí nghiệm hoặc trên đường vận chuyển đến khu vực xử lý. Khi sử dụng các phụ kiện tiệt trùng phù hợp, phương pháp hấp tiệt trùng mô tả ở trên sẽ vô hiệu hóa vi sinh vật nguy hại trong khi vẫn giữ được độ sạch sẽ tối đa.
Trong trường hợp này, cần lựa chọn các túi chứa rác thải sinh học phù hợp.
Giải pháp tiệt trùng đĩa petri nuôi cấy agar – Nồi hấp tiệt trùng ALP
Nồi hấp tiệt trùng ALP CL Series và CLG series được sử dụng phổ biến trong các phòng thí nghiệm Dược phẩm, Thực phẩm, Mỹ phẩm, Trường học hay các Cơ sở nghiên cứu, …. Nồi hấp tiệt trùng ALP dòng CL và CLG- series được trang bị nhiều tính năng đảm bảo độ tin cậy cho quá trình tiệt trùng đĩa petri nuôi cấy agar, cũng như đảm bảo tính an toàn cho người sử dụng.
Dòng CL series của ALP từ lâu đã khẳng định vị thế là nồi hấp tiệt trùng (top-loading) bán chạy nhất, nổi bật với hiệu suất ổn định và giá cả cạnh tranh. Tiếp nối thành công đó, CL-DP series được bổ sung chức năng sấy khô hiệu quả, đáp ứng nhu cầu đa dạng.
![]() |
Ưu Điểm Của Nồi hấp ALP Dòng CL Series
✓ Giá cả cạnh tranh, chất lượng Nhật Bản. ✓ Khóa nắp liên động an toàn một thao tác. ✓ 3 chế độ: Tiệt trùng, Tiệt trùng/Ủ ấm, Hòa tan/Ủ ấm. |
Dòng CLG series là bước tiến vượt trội, mang đến giải pháp tiệt trùng cao cấp với chu trình SFPP (Xả Hơi – Xung Áp Suất) tiên tiến , tối ưu cho các vật liệu phức tạp.
![]() |
Ưu Điểm Vượt Trội Của CLG Series:
✓ Công Nghệ SFPP Đột Phá Loại bỏ không khí hiệu quả bằng cách luân phiên xả hơi và xung áp suất, đảm bảo hơi nước thẩm thấu tối đa. ✓ Độ Bền Vượt Trội Linh kiện cao cấp (gioăng chịu hơi, thanh đốt inox) giảm chi phí vận hành. ✓ Màn Hình LCD Tương Tác Hiển thị chi tiết, dễ dàng thao tác và theo dõi nhiệt độ, thời gian, áp suất. ✓ Chương Trình Đa Dạng & Tùy Chỉnh 5 chương trình cài sẵn và 10 bộ nhớ tùy chỉnh linh hoạt. |
Kết luận
Tiệt trùng đĩa Petri và agar bằng nồi hấp tiệt trùng là quy trình còn vô cùng quan trọng để duy trì an toàn phòng thí nghiệm và bảo vệ môi trường. Tuân thủ đúng quy trình và nguyên lý kể trên sẽ giúp quá trình tiệt trùng đĩa petri đã qua sử dụng đạt hiệu quả tối đa, vô hiệu hóa hiệu quả các vi sinh vật có hại, giảm thiểu nguy cơ ô nhiễm và đảm bảo quy trình xử lý an toàn, sạch sẽ. Công ty TNHH Thiết bị Hiệp Phát hiện đang là Master Distributor – Nhà phân phối ủy quyền các dòng nồi hấp tiệt trùng cao cấp hãng ALP – Nhật Bản. Nếu quý khách hàng đang có nhu cầu tìm mua các dòng nồi hấp tiệt trùng ALP, đừng ngần ngại liên hệ với Hiệp Phát qua Sđt: 0919.537.653 – Mr. Tú hoặc Email: sales5@thietbihiepphat.com để được hỗ trợ kịp thời.
Để lại thắc mắc, chúng tôi sẽ giải đáp ngay cho bạn
VN

